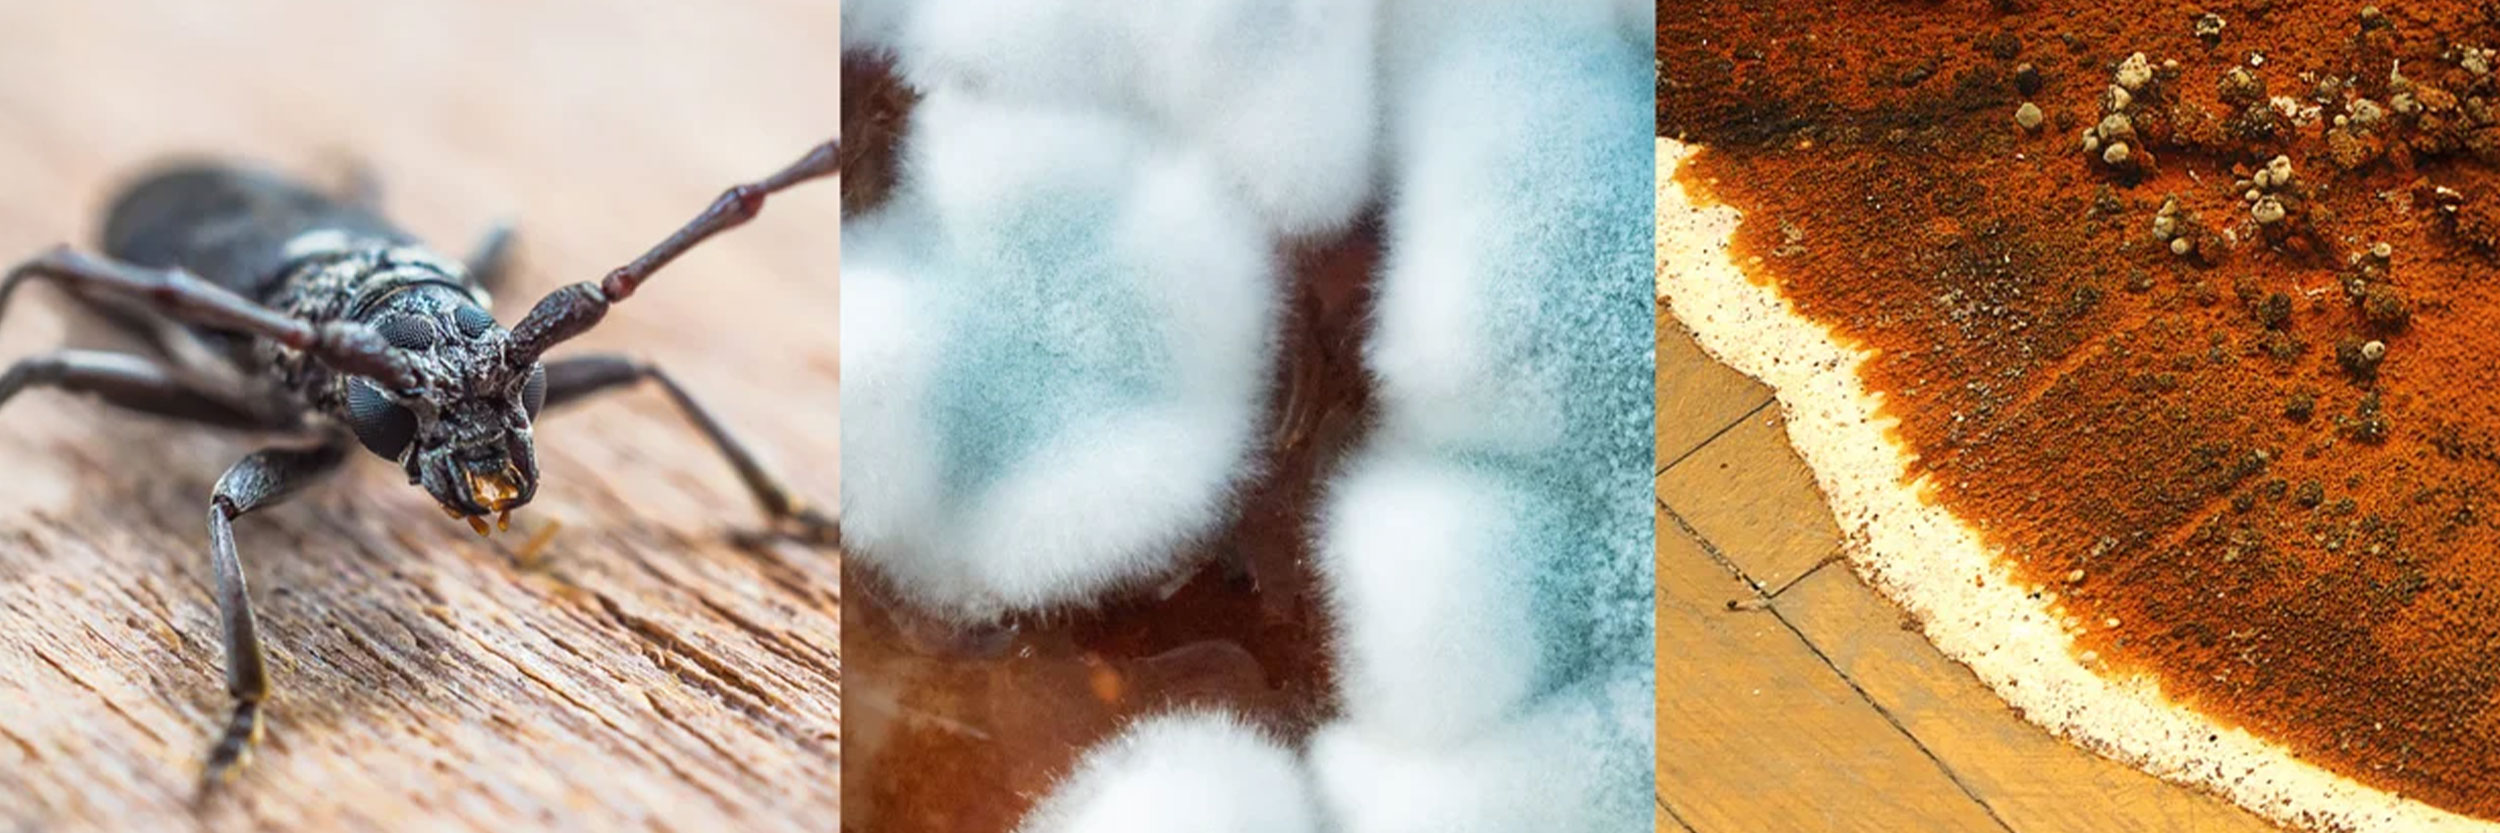
Toppbild Insekt 2500X833

Uppgradera ditt träskydd till en helt nu nivå. Med ProtoxKombi Aqua sparar du tid och kan därmed utföra dina uppgifter mer effektivt. Produkten är en kombinationsprodukt som klarar flera uppgifter i en behandling. Sluta behandla separat för insekts-, svamp- och mögelangrepp. ProtoxKombi Aqua tar på sig an alla dessa uppgifter i en enda samlad behandling.
Fördelar
Behandlar: Skyddar långt efteråt!
Stoppar svampen i tid: Hindrar den från att komma tillbaka.
En kraftfull allt-i-ett-lösning: Gör jobbet snabbt och effektivt.
Användningsområden
Uppgradera ditt träskydd till en helt nu nivå med ProtoxKombi Aqua - den förebyggande och kraftfulla allt-i-ettlösningen mot trädnedbrytande svampar, insekter och mögel. Säg adjö till oron för husbock, äkta hussvamp och mögelticka, för ProtoxKombi Aqua ger ditt trä den ultimata skyddsnivån.
ProtoxKombi Aqua är en innovativ produkt som effektivt förebygger alla angrepp av trädnedbrytande svampar, insekter och mögel. Det är den ultimata lösningen för att säkerställa att ditt trä förblir starkt och hållbart över tid.
Bruksanvisning
Rör om innan användning. Applicera med pensel eller roller. Torktid cirka 24 timer vid 23°C och relativ fukt på 60 %.
Spädning & åtgång
ProtoxKombi Aqua är färdig att använda och skall ej spädas. Förbrukning förebyggande behandling, 0,2 liter per m².